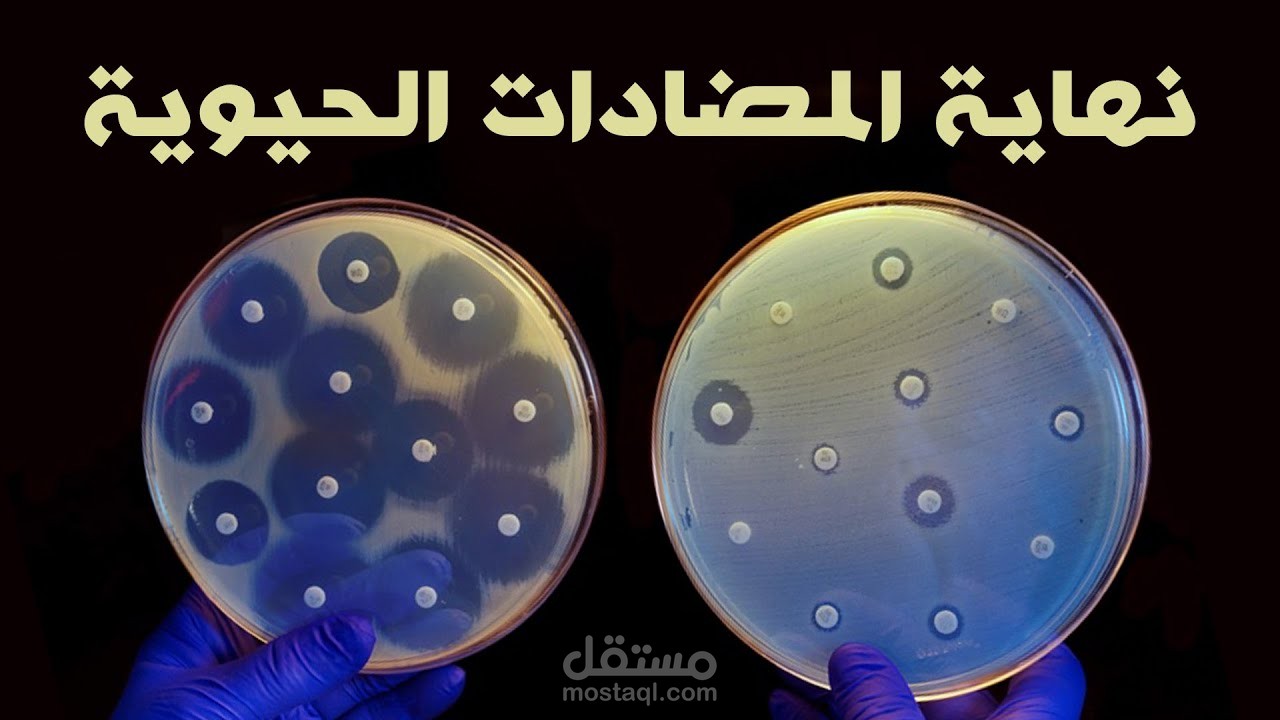
مناعة البكتريا للمضادات الحيوية | صراع مصيره إبادة الملايين

Ehab G.
نبذة عني
اعمل في مجال مونتاج الفيديو منذ 5 سنوات
ولي أكثر من 515 فيديو على اليوتيوب فقط في أشهر القنوات العربية ستجدهم في معرض أعمالي
وحاليا أعمل مع 3 منهم
الأولى بها 3.69 مليون مشترك
والثانية بها 1.39 مليون مشترك وأنا المونتير الوحيد لها
والثالثة ها 2.25 مليون مشترك
استطيع انتاج كافة انواع الفيديوهات.
كل ما تحتاجه لصناعة الفيديو الخاص بك بشكل احترافي ولافت للنظر
-تحويل صورة الى فيديو
-تصحيح الوان واضافة مؤثرات الوان
-مؤثرات بصرية
-اضافة مؤثرات صوتية
-اضافة مقطوعات موسيقية ( لا تحوي على حقوق ملكية لعدم رفضها من قبل يوتيوب )
-قص وترتيب وتركيب الفيديوهات والصور والاصوات الخاصة بك بشكل احترافي
-استلام جودة عالية Full HD 1080p
امثلة لانواع الفيديوهات التي يتم انتاجها
-اعلانات وفيديوهات دعائية
-فيديوهات موسيقية (Music videos)
-فيديوهات روائية ووثائقية
-فيديوهات لليوتيوبرز